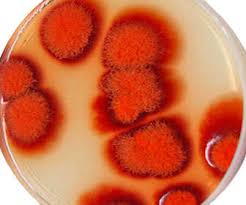

Фотографии гриба Blakeslea trispora

Раздел: Природная галерея